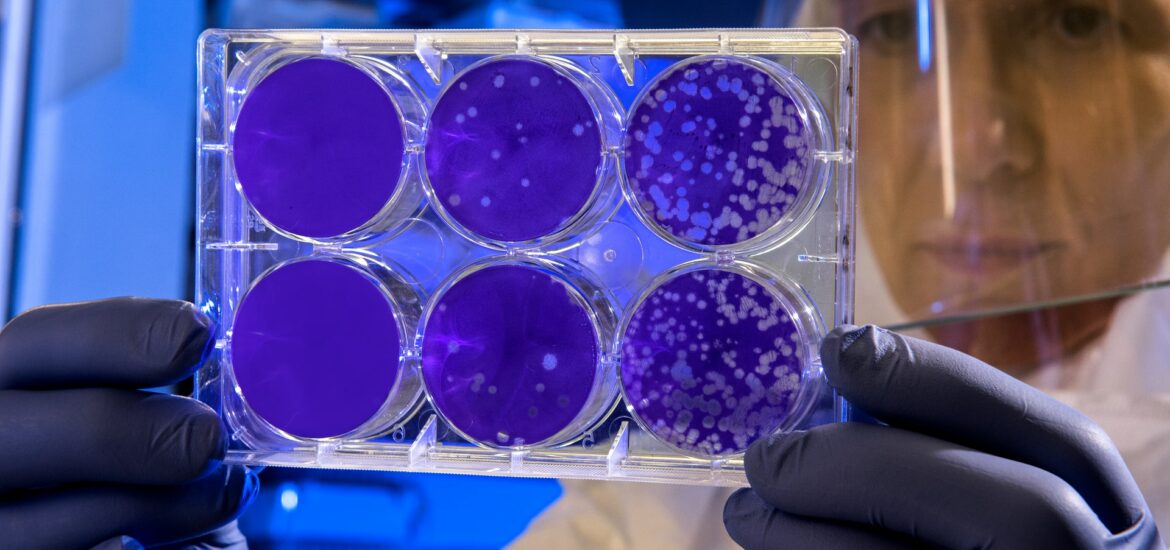

Chi ha già avuto il Covid e ha quindi sviluppato gli anticorpi o è doppiamente vaccinato con Pfizer/BioNTech non può dirsi immune dall’infezione, soprattutto con il diffondersi di Omicron. A sostenerlo è un gruppo di ricerca guidato dal Leibniz Institute for Primate Research di Gottingen in Germania insieme ai ricercatori della Hanover Medical School, Gottingen University Medical Center, Università Friedrich-Alexander di Erlangen-Norimberga e Centro tedesco per la ricerca sulle infezioni di Braunschweig.
L’OBIETTIVO DELLO STUDIO
Il team, per valutare l’efficacia delle vaccinazioni e degli anticorpi terapeutici, ha studiato sia l’efficacia degli anticorpi prodotti naturalmente dal nostro organismo una volta guariti dal Covid che quelli prodotti da due dosi di vaccino.
I RISULTATI SUI VACCINI
Dallo studio, riferisce Agi, è emerso che gli anticorpi prodotti dopo due iniezioni di Pfizer/BioNTech erano significativamente meno efficaci contro la variante Omicron rispetto alla variante Delta, tuttora considerata dominante.
“Gli anticorpi che si sono formati dopo due immunizzazioni con il vaccino Pfizer/BioNTech – spiegano gli esperti – hanno inibito la proteina spike di Omicron in modo significativamente peggiore rispetto alle proteine spike di altre varianti”.
Sarebbe risultata, invece, una migliore inibizione a seguito della dose di richiamo (booster) effettuata sempre con Pfizer/BioNTech, ma anche con la vaccinazione eterologa se svolta con AstraZeneca.
Questi risultati indicano dunque che la doppia immunizzazione con Pfizer/BioNTech potrebbe non proteggere dalla variante Omicron come invece accade con la variante Delta.
I RISULTATI SUGLI ANTICORPI
Il team ha inoltre notato che la maggior parte degli anticorpi terapeutici utilizzati per il trattamento del Covid ed esaminati nello studio non sono efficaci contro la variante Omicron. “I nostri studi sulle colture cellulari suggeriscono che la maggior parte degli anticorpi attualmente disponibili per la terapia Covid contro Omicron sarà inefficace”, ha detto l’autore principale dello studio, Markus Hoffmann.
Attualmente per il trattamento del Covid vengono spesso utilizzate combinazioni degli anticorpi casirivimab e imdevimab, nonché etesvimab e bamlanivimab.
Tuttavia, i test hanno mostrato che questi anticorpi erano in gran parte inefficaci contro il picco di Omicron. Solo sotrovimab avrebbe inibito la variante: “Sotrovimab è un’eccezione – ha aggiunto Hoffmann – e potrebbe diventare una parte importante del trattamento dei pazienti infettati da Omicron”.
I RISULTATI SUGLI ANTICORPI DA INFEZIONE
I ricercatori hanno anche studiato se le persone che erano state infettate durante la prima ondata in Germania avessero prodotto anticorpi che proteggono dalla variante Omicron. Dallo studio è emerso che sebbene gli anticorpi abbiano inibito il picco del virus responsabile della prima ondata, hanno avuto scarso effetto sul picco di Omicron.
Uno studio di metà dicembre dell’Imperial College di Londra aveva addirittura notato che la probabilità per i guariti di subire un’infezione da Omicron è cinque volte più alta rispetto a quella comportata dalla variante Delta.
COSA SUGGERISCONO I RICERCATORI
Il team che ha condotto lo studio in Germania ha concluso che le terapie anticorpali per il Covid oggi disponibili dovrebbero essere adattate a Omicron e “dovrebbe essere preso in considerazione anche un adattamento del vaccino Pfizer/BioNTech”.